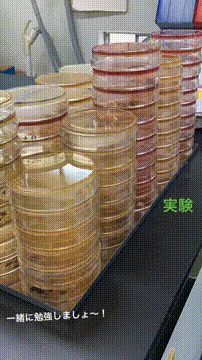
OCカメラサムネイル画像
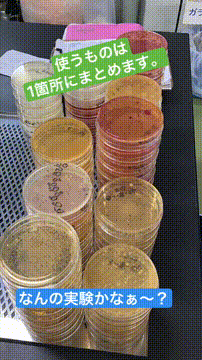
OCカメラサムネイル画像
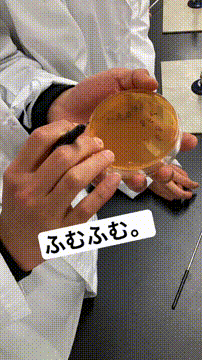
OCカメラサムネイル画像

東京栄養食糧専門学校からのメッセージ
2025年4月4日に更新されたメッセージです。
★管理栄養士 国家試験 結果について★
今年度は、全国専門学校の管理栄養士養成施設の中で最も多い合格者数かつ、都内専門学校の中で、合格率が1番良い結果となりました。
本校(管理栄養士科)の受験者数は67名のうち合格者数53名、合格率は79.1%でした。
(全国の受験者数16,169名のうち合格者数は7,778名、合格率は48.1%)
受験者の学生全員、お疲れ様でした!
そして合格した皆さん、おめでとうございます!!
東京栄養食糧専門学校で学んでみませんか?
東京栄養食糧専門学校はこんな学校です
東京栄養食糧専門学校は学ぶ内容・カリキュラムが魅力

実践的な授業を重視。「企業連携」の授業も!
実践的な授業を重視することで、理解力を深め、調理技術も高めます。美味しい料理のできる栄養士・管理栄養士の養成も教育モットーの一つです。また、学外で学ぶ臨地・校外実習をカリキュラムに導入し、実践の場である事業所や病院などの施設で学習することで、給食運営の実態を体得するとともに大量調理における栄養士業務や役割について更に理解を深めます。80年を超える伝統校だからこその豊富な実習先で、現場のスタッフと共に働き、仕事内容を理解し、将来の目標を明確にします。
東京栄養食糧専門学校は施設・設備が充実

本格的な施設・最先端の設備で学び、即戦力として活躍できる栄養士へ!
国際的に認められた衛生管理システムで、NASA(米国航空宇宙局)が宇宙食の安全性を確保するために開発した、HACCP(ハサップ)を給食管理実習室に導入しています。また、栄養と運動の両面から健康づくりを考えることができる栄養士・管理栄養士になるため、総合的運動施設(フィットネスジム、エアロビクススタジオなどの要素を含む)も完備しています。
東京栄養食糧専門学校は資格取得に有利

専門学校トップクラスの合格者数を誇る『管理栄養士国家試験合格者数』
管理栄養士科では、国家試験対策講座やワークショップ方式による演習、インターネット環境があれば自宅や学校からでも自由に学習できるe-ラーニングの導入、模擬試験などサポート体制を整えています。また、栄養士科卒業後に、管理栄養士科の3年次に編入し、受験を目指すこともできます。また、管理栄養士・栄養士の資格のみならず、一都三県の専門学校で本校のみ取得できる「栄養教諭一種・ニ種免許状<国>」や「介護職員初任者研修修了者」などの資格取得も目指せます。
あなたは何を学びたい?
東京栄養食糧専門学校の学部学科、コース紹介
東京栄養食糧専門学校の評判や口コミは?
在校生の声が届いています
-

目指すは調理のできる管理栄養士。保育園で子どもの食育に携わりたい!
- 管理栄養士科 健康・食育コース
東京栄養食糧専門学校の卒業後のキャリアや就職先は?
卒業生の声が届いています
-

アスリートがベストコンディションで試合に臨めるよう、身近な「食」からサポート!
- 管理栄養士科
- 管理栄養士
-

幼児期の食育に携わりながら、子どもたちの健やかな成長を見守っています
- 栄養士科 こども・食育コース
- 栄養士
東京栄養食糧専門学校の就職・資格
東京栄養食糧専門学校の卒業後の進路データ (2024年3月卒業生実績)
就職希望者数156名
就職者数153名
就職率98.1%(就職者数/就職希望者数)
学生一人ひとりと向き合うきめ細かな就職指導
本校では、毎年高い就職決定率を誇っています。就職担当とキャリア支援室との綿密な連携で学生が希望する就職先へと最大限バックアップします。高い就職決定率の理由は本校自慢の手厚いサポート。履歴書の添削・面接指導などを行う講座、挨拶や姿勢、社会に出る上で身につけたいマナー講座などもサポートの一つ。本校ならではの学内企業研究会は企業の人事担当者から直接就職活動をサポートいただけるシステム。これらのサポートを、学生一人ひとりにきめ細かく指導が行えるのも伝統校だからこそです。
気になったらまずは、東京栄養食糧専門学校のオープンキャンパスにいってみよう
東京栄養食糧専門学校のOCストーリーズ
東京栄養食糧専門学校のイベント
-

開催時間:11:00~13:30 管理栄養士科2年生が運営する給食へ特別にご招待! 【メニュー】 ◇豆腐と卵のあんかけ丼 ◇ささみの胡麻和え ◇胡瓜とじゃこの酢の物 ◇ミルク味噌汁 ◇柚子ゼリー ※保護者様のみのご参加はご遠慮願います。 ご検討者様同伴でのご参加をお願いいたします。 ※同伴者様がいる場合、必ず入力をお願いいたします。 ※食数に限りがございますので必ずご予約の上ご参加ください。 :::*:::*:::*:::*:::*:::*:::*:::*:::*:::*:::*:::*:::*:::*:::*:::*:::*:::*:::*::: ▼学校説明 ▼校内見学:校内の施設をチェックしながらまわりましょう! ▼ランチ(給食):学生が作る給食を食べてみよう♪ ▼個別相談:気になることは全て解消しましょう! :::*:::*:::*:::*:::*:::*:::*:::*:::*:::*:::*:::*:::*:::*:::*:::*:::*:::*:::*:::*:::* \★2025年度オープンキャンパス参加特典★/ ■入学検定料2万円が免除! 出願までにオープンキャンパス等に2回以上参加の方は入学検定料が免除 ■交通費補助制度 条件を満たした場合、一部地域に限りご利用いただけます。
-

開催時間:10:30~13:30 同日開催で行われている「実習体験」と「講座体験」どちらか選んで参加しよう♪ ★選択体験【講義】チーズ講座 栄養と発酵を学ぼう! チーズの奥深いカラクリについて学びます。さらに私たちの体づくりに大切な栄養素カルシウムの秘密と必要性に迫ります。 :::*:::*:::*:::*:::*:::*:::*:::*:::*:::*:::*:::*:::*:::*:::*:::*:::*:::*:::*::: ▼学校説明&就職・入試説明 ▼模擬授業:栄養士・管理栄養士を理解するための模擬授業 ▼個別相談:気になることは全て解消しましょう! :::*:::*:::*:::*:::*:::*:::*:::*:::*:::*:::*:::*:::*:::*:::*:::*:::*:::*:::*:::*:::* \★オープンキャンパス参加特典★/ ■入学検定料2万円が免除! 出願までにオープンキャンパス等に2回以上参加の方は入学検定料が免除 ■交通費補助制度 条件を満たした場合、一部地域に限りご利用いただけます。
東京栄養食糧専門学校の所在地・アクセス
| 所在地 | アクセス | 地図 |
|---|---|---|
| 東京都世田谷区池尻2-23-11 |
東急田園都市線(地下鉄半蔵門線直通)「池尻大橋」駅より東口を出て徒歩 5分 |
東京栄養食糧専門学校で学ぶイメージは湧きましたか?
つぎは気になる学費や入試情報をみてみましょう
東京栄養食糧専門学校の学費や入学金は?
初年度納入金をみてみよう
2026年度納入金 【栄養士科】146万円(別途諸経費15万円、教科書代7万円程度)/【管理栄養士科】152万円(別途諸経費14万円、教科書代7万円程度)/【健康スイーツ研究科】114万円(別途諸経費10万円、教科書代5万円程度)
東京栄養食糧専門学校の関連ニュース
東京栄養食糧専門学校に関する問い合わせ先
学校法人 食糧学院 学院広報室
〒154-8544 東京都世田谷区池尻2-23-11
TEL:03-3424-9112